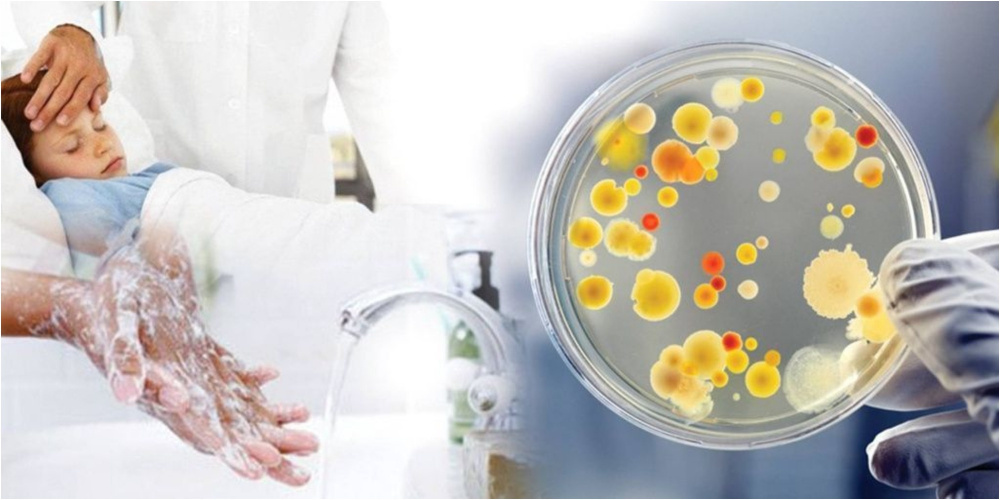

ВОЗ: Ежедневно регистрируется около пяти тысяч новых случаев заражения гепатитом
Глобальные усилия по борьбе с вирусным гепатитом приносят ощутимые результаты – число новых случаев заражения и смертельных исходов существенно снижается. Однако заболевание по-прежнему остается одной из серьезнейших угроз для здоровья населения во всем мире. Об этом говорится в новом докладе Всемирной организации здравоохранения (ВОЗ), представленном на Всемирном саммите по борьбе с гепатитом.
Распространение инфекции
По данным ВОЗ, вирусные гепатиты B и C, на которые приходится 95% всех смертей, связанных с гепатитом, унесли в 2024 году 1,34 млн жизней. При этом передача инфекции продолжается – ежедневно регистрируется более 4 900 новых случаев заражения, или 1,8 млн в год.
Значительный прогресс
В новом докладе отмечается значительный прогресс с 2015 года. Число новых случаев гепатита B сократилось на 32%, а смертность от гепатита C снизилась на 12%. Эти успехи стали возможны благодаря совместной работе на глобальном и национальном уровнях после того, как государства - члены ВОЗ в 2016 году утвердили цели по ликвидации вирусного гепатита. Вместе с тем в организации предупреждают – нынешних темпов недостаточно для достижения всех поставленных целей к 2030 году.
Необходимо ускорить меры по профилактике, тестированию и лечению.
Цель – ликвидация гепатита
"Страны по всему миру доказывают, что ликвидация гепатита – это не несбыточная мечта, а реальная цель при наличии политической воли и финансирования", – заявил генеральный директор ВОЗ Тедрос Гебрейесус. При этом, по его словам, прогресс остается слишком медленным и неравномерным, а миллионы людей по-прежнему не проходят диагностику и не получают необходимое лечение из-за стигматизации, недостаточной эффективности систем здравоохранения и неравного доступа к медицинской помощи.
Ситуация в разных странах
Так, несмотря на достигнутый прогресс, ограниченный доступ к профилактике и медицинской помощи по-прежнему приводит к высоким показателям смертности. В 2024 году, по оценкам, от гепатита B умерли около миллиона человек, а от гепатита C – 240 тыс.
Основными причинами смертности остаются цирроз печени и гепатоцеллюлярная карцинома.
Особенно высокие показатели смертности от гепатита B зафиксированы в ряде стран. Так, на Бангладеш, Китай, Эфиопию, Гану, Индию, Индонезию, Нигерию, Филиппины, Южную Африку и Вьетнам пришлось 69% всех смертей от гепатита B в мире в 2024 году. В то же время смертность от гепатита C распределена более широко географически: 58% всех случаев пришлись на Китай, Индию, Индонезию, Японию, Нигерию, Пакистан, Россию, Южную Африку, Соединенные Штаты Америки и Вьетнам.
Несмотря на сохраняющиеся трудности, успехи Египта, Грузии, Руанды и Великобритании показывают, что ликвидация гепатита как угрозы общественному здоровью возможна при наличии политической воли и инвестиций. Для этого уже существуют эффективные инструменты.
Эффективные инструменты
Так, вакцина против гепатита B обеспечивает более чем 95-процентную защиту, а современные препараты позволяют контролировать хронический гепатит B и излечивать более 95% случаев гепатита C.
В ВОЗ призывают ускорить интеграцию профилактики, диагностики и лечения гепатита в системы первичной медико-санитарной помощи, расширить охват вакцинацией новорожденных и усилить программы снижения вреда для людей, употребляющих инъекционные наркотики.
Фото на главной странице иллюстративное: neplacebo.ru.